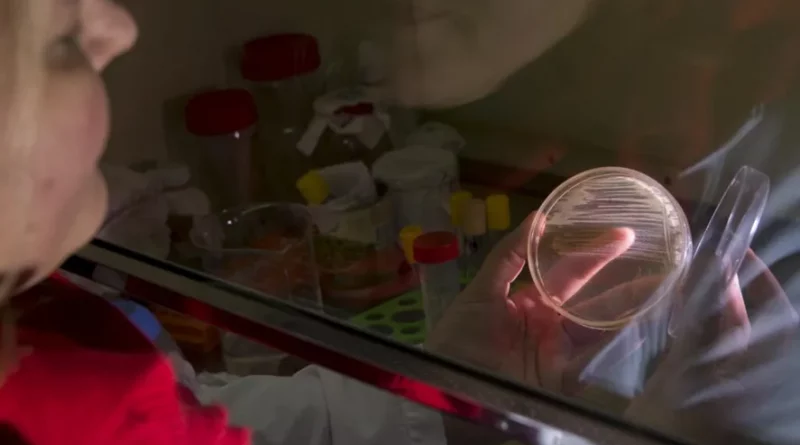

Según el estudio de dos universidades, existen sitios vulnerables en la estructura de las bacterias del complejo Burkholderia cepacia que pueden ser aprovechados “como blancos para combatir microorganismos”. Se trata de microorganismos que pueden contaminar tanques de agua y que representan un gran problema de salud pública al causar infecciones crónicas.
Un equipo internacional conformado por científicos de la Universidad Nacional de La Plata (UNLP) y de la Universidad de Manitoba, Canadá, reveló que existen sitios vulnerables en la estructura de las bacterias del complejo Burkholderia cepacia, que pueden ser aprovechados “como blancos para combatir microorganismos, a pesar de su multirresistencia a los antibióticos”.
Según explicaron desde la UNLP, las bacterias del complejo Burkholderia cepacia son de relevancia en Argentina y “comprenden diversas especies que poseen una amplia distribución ambiental, una extraordinaria versatilidad metabólica, genomas complejos y de gran tamaño, y una alta tasa de mutación que les permite adaptarse rápidamente a diferentes entornos”.
Además, estas bacterias presentan resistencia a los antibióticos y antisépticos, así como una notable capacidad para sobrevivir en condiciones de escasez de nutrientes, llegando incluso a utilizar ciertos antimicrobianos como fuente de carbono para su supervivencia.
“Estos rasgos son los que hacen que estas bacterias puedan contaminar exitosamente tanques de agua, formulados farmacéuticos y productos que contienen biocidas, además de representar un gran problema de salud pública al causar infecciones crónicas recalcitrantes y multirresistentes en personas con fibrosis quística, en pacientes hospitalizados y en individuos inmunocomprometidos”, informaron los especialistas.
La investigación
Así es que en agosto del 2023, el equipo de la doctora Silvia Cardona, argentina radicada en Canadá, junto a la doctora Alejandra Bosch y una de sus becarias, doctora Beltina León, investigadoras del Centro de Investigación y Desarrollo en Fermentaciones Industriales (CINDEFI), dependiente de la Facultad de Ciencias Exactas de la UNLP y del Conicet, publicaron un artículo en la revista científica Nature Communications.
El trabajo estudia la interacción de diferentes tipos de antibióticos con la envoltura celular de bacterias de ese complejo y “revela nuevas estrategias para combatir las infecciones por bacterias gram negativas multirresistentes a antibióticos”.
“La envoltura celular de estos organismos constituye una barrera única que impide la penetración de antimicrobianos y son la principal causa de su múltiple resistencia. La resistencia intrínseca de estas bacterias a las diferentes clases de antimicrobianos limita severamente las opciones de tratamiento”, dijeron.
Agregaron que “los antibióticos del grupo de los β-lactámicos constituyen hoy las armas más poderosas en la lucha contra estas especies bacterianas. Sin embargo, las tazas de resistencia se han ido incrementando en el tiempo y actualmente son mayores al 50%. Esta investigación, buscó intervenir en la mejora de las terapias antimicrobianas para combatir estas bacterias multirresistentes”, explicó Bosch.
El trabajo presenta los resultados de un estudio que permitió identificar elementos de resistencia y susceptibilidad asociados a la envoltura celular en organismos del Complejo Burkholderia cepacia.
Seguí leyendo:
Bioquímica argentina estudia superbacteria con alta tasa de mortalidad y resistente a antibióticos
Científicos de Córdoba desarrollan material inteligente que libera antibióticos